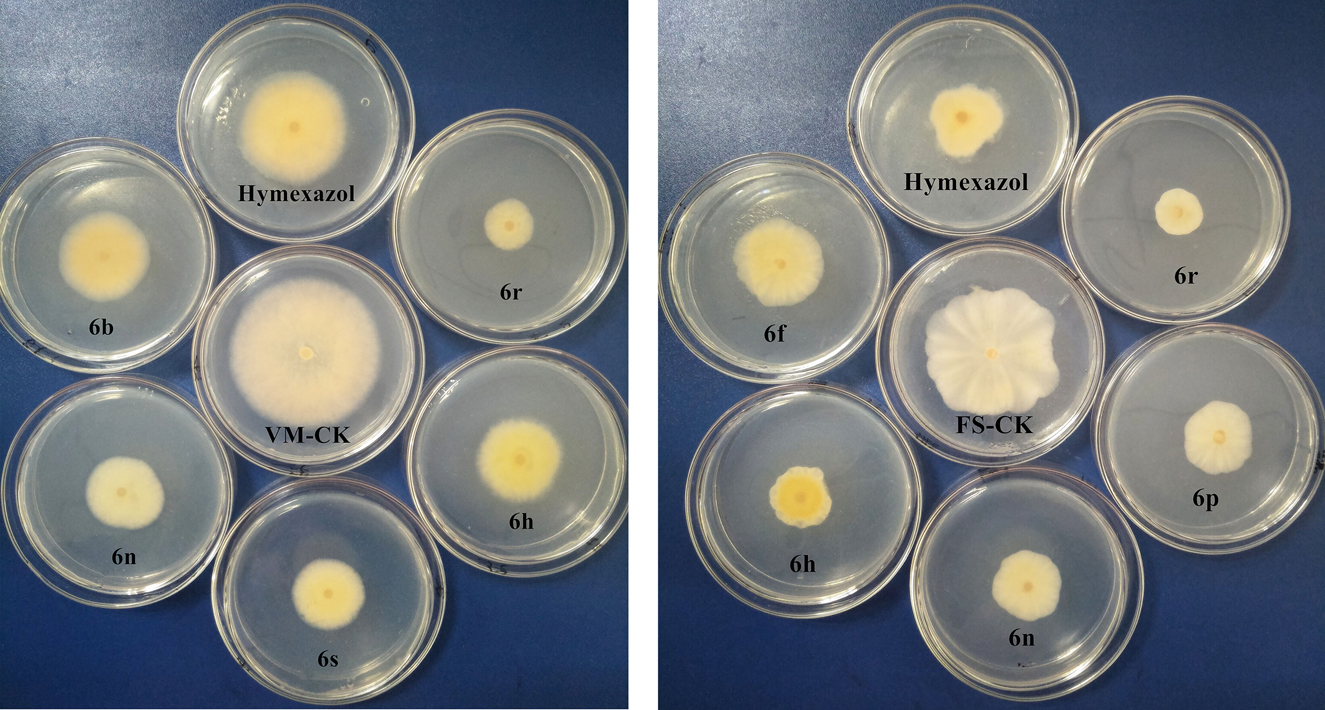
Figure 2: Effects of compounds on the growth of Valsa mali (VM) and Fusarium sulphureum (FS) (CK: blank control group).

Abstract
In order to obtain novel botanical fungicides, three series of novel 6-substituted n-butyphthalide derivatives have been designed and synthesized via nucleophilic addition, reduction, nitrification, amination, sulfonation, Sandmeyer and Suzuki reaction. The mycelium growth rate method was used to evaluate the inhibition activity against eight phytopathogenic fungi in vitro. Preliminary bioassay tests showed that compounds 6f, 6n, 6p, 6r and 7a exhibited better activity for some fungi at 50 μg/mL than the positive drug hymexazol and lead compound n-butyphthalide (NBP). The preliminary structure–activity relationships indicated that the antifungal activity is significantly affected by the substituents on the benzene ring.
1 Introduction
Plant disease is a natural disaster caused by plant pathogenic fungi, which not only tremendously influence the yield and quality of grain, vegetables and fruits, but also some pathogenic fungi can produce carcinogenic, neurotoxic or teratogenic secondary metabolites (such as aflatoxin and zearalenone) in the process of growth and metabolism in the host body. Therefore, the development of novel compounds that effectively inhibit these agricultural diseases is still highly desirable [1]. Phthalides are a relatively small group of natural compounds found in several plant and fungal genera, which usually possess a broad scope of pharmacological and biological activities [2], [3], such as the three compounds (Z)-butylidenephthalide (1), n-butylphthalide (2) and (Z)-ligustilide (3) (Figure 1). Identified in the essential oil of Lingusticum chuanxiong, these were shown to exhibit antifungal [4], antiplatelet [5], neuroprotection [6], anticancer [7], anti-inflammatory [8] and insecticidal effects [9], [10]. However, to the best of our knowledge, phthalide compounds were rarely reported on their structural modifications based on agricultural bioactivities. Thus, in continuation of our aim to search for novel bioactive molecules with antiphytopathogenic effects [11], [12], [13], [14], [15], [16], we selected n-butylphthalide as the lead compound. Three series of 6-substitued phthalide derivatives were designed, synthesized and evaluated for their antifungal activities against eight phytopathogenic fungi in vitro.

The structure of some phthalides and their biological activities.
2 Results and discussion
As shown in Scheme 1, the lead compound n-butylphthalide (2) was synthesized according to our previous method. (Z)-butylidenephthalide (1) was prepared by the nucleophilic addition of phthalic anhydride with n-BuLi, followed by dehydration in toluene with p-toluenesulfonic acid (p-TsOH) as catalyst. Then compound 2 was obtained by the treatment of compound 1 with Pd/C in 94.5% yield [17]. Afterward, compound 2 was nitrated using potassium nitrate in H2SO4 to obtain the corresponding nitro compound 3, which was reduced with iron powder and NH4Cl in THF/H2O to give amino compound 4 [18]. Compound 4 was subjected to standard Sandmeyer reactions to give the 6-bromobutylphthalide (5). Finally, the target compounds 6a–s were prepared by suzuki reaction of compound 5, and compounds 7a–f and 8a–c were synthesized by sulfonylation and acylation reaction of compound 4 (Scheme 2). All the target compounds are new compounds and their structures were characterized by spectrometric methods including 1H NMR, 13C NMR and high-resolution mass spectra (HRMS).

Synthetic route for the target compounds 6a–s.

Synthetic route for the target compounds 7a–f and 8a–c.
Using the commercially available agricultural fungicide hymexazol as the positive control, the antifungal activity in vitro of compounds 6a–s, 7a–f and 8a–c were assayed according to the mycelium growth rate method. Eight plant pathogenic fungi Fusarium sulphureum (FS), Thanatephorus cucumeris (TC), Fusarium oxysporum (FO), Fusarium graminearum (FG), Botrytis cinerea (BC), Valsa mali (VM), Sclerotiua sclerotiorum (SS) and Alternaria solani (AS) were used as tested fungi.
As is shown in Table 1, most of the derivatives displayed certain inhibitory effects on the growth of the tested phytopathogenic fungi. Compounds 6h, 6n, 6p and 6r showed the good antifungal activity against FS with the inhibition values of 56.0–72.0%, which were better than the positive compound hymexazol (55.9%), but inferior to the lead compound n-butylphthalide (76.5%). Unfortunately, all the target compounds possessed rather weak activity against TC strains except 6r (62.4%). For FO strains, compound 6f (55.9%) showed the similar fungicidal activity with NBP (59.4%), and compounds 6a (46.8%), 6r (47.8%), 6s (46.8%), 7a (45.1%) and 7e (49.2%) had a slightly lower value than that of 6f. For FG strains, seven compounds (6a, 6b, 6f, 6k, 6n, 6p and 6r) exhibited relatively higher activity (44.4–65.8%) than hymexazol (42.4%), especially the activity of compound 6n (65.8%) was close to that of NBP (69.2%). Furthermore, compounds 6a, 6f, 6n, 6o, 6p, 6r and 7a also showed better antifungal activity (50.7–79.0%) against AS than that of hymexazol (48.3%) and NBP (50.2%). Toward BC strains, it was worth mentioning that except compounds 8a–c, all derivatives generally exhibited more pronounced antifungal activity (>21.2%) than the lead compound NBP (13.2%), especially the activity of compound 6e (82.3%) was significantly superior to that of hymexazol (69.2%). For SS strains, only the activity of compound 6r (70.7%) was comparable to NBP (68.0%) and hymexazol (68.4%). Moreover, all the target compounds except 8a–c exhibited better antifungal activity against VM than the positive compound hymexazol (10.1%), but failed to exceed that of NBP (63.2%) except for 6r (74.3%). In general, compounds 6a, 6f, 6n, 6r, 6s and 7a displayed good and broad-spectrum antifungal activities against several phytopathogenic fungi.
Antifungal activities of compounds 6a–s, 7a–f, and 8a–c at 50 μg mL−1.
| Compounds | Average inhibition rate ± SD (%) (n = 3) | ||||||||
|---|---|---|---|---|---|---|---|---|---|
| No. | R | FS | TC | FO | FG | BC | VM | SS | AS |
| 6a | Ph | 47.3 ± 1.4 | 38.6 ± 0.8 | 46.8 ± 1.6 | 44.4 ± 1.4 | 53.8 ± 3.5 | 51.9 ± 0.9 | 40.4 ± 1.7 | 53.6 ± 1.4 |
| 6b | 4-CH3Ph | 37.3 ± 1.4 | 28.6 ± 0.4 | 26.2 ± 2.7 | 48.6 ± 1.6 | 38.6 ± 2.3 | 48.7 ± 0.9 | 31.9 ± 1.4 | 44.2 ± 1.1 |
| 6c | 4-EtPh | 32.5 ± 0.5 | 38.0 ± 0.4 | 23.0 ± 1.4 | 31.9 ± 1.4 | 32.6 ± 2.6 | 21.7 ± 0.4 | 36.2 ± 1.4 | 26.1 ± 1.4 |
| 6d | 4-NH2Ph | 34.0 ± 2.4 | 18.3 ± 1.7 | 22.5 ± 1.4 | 13.6 ± 1.6 | 30.3 ± 2.6 | 24.9 ± 1.9 | 17.4 ± 0.2 | 31.9 ± 2.1 |
| 6e | 4-OHPh | 42.7 ± 3.6 | 17.6 ± 0.7 | 39.2 ± 1.4 | 37.2 ± 1.4 | 82.3 ± 1.3 | 43.1 ± 1.6 | 61.6 ± 0.6 | 37.0 ± 2.4 |
| 6f | 2-FPh | 52.3 ± 1.8 | 43.5 ± 0.9 | 55.9 ± 0.6 | 46.1 ± 1.1 | 62.1 ± 1.3 | 49.2 ± 2.7 | 39.3 ± 0.8 | 50.7 ± 2.7 |
| 6g | 2-F, 4-OCH3Ph | 19.0 ± 2.4 | 27.2 ± 0.8 | 18.0 ± 1.6 | 30.6 ± 1.2 | 24.6 ± 0.7 | 28.0 ± 0.9 | 27.1 ± 3.2 | 36.2 ± 3.4 |
| 6h | 2-F, 4-CHOPh | 61.3 ± 1.4 | 38.0 ± 2.4 | 25.2 ± 1.6 | 31.9 ± 1.4 | 42.4 ± 1.3 | 58.2 ± 1.6 | 32.9 ± 0.8 | 23.9 ± 0.6 |
| 6i | 3- CF3Ph | 38.7 ± 0.5 | 29.6 ± 1.4 | 16.2 ± 2.7 | 22.6 ± 1.6 | 27.3 ± 2.3 | 28.0 ± 2.4 | 31.4 ± 0.8 | 29.0 ± 2.7 |
| 6j | 4-OCF3Ph | 21.4 ± 2.5 | 20.0 ± 1.1 | 19.4 ± 2.8 | 26.6 ± 1.3 | 32.2 ± 2.4 | 17.7 ± 1.2 | 18.4 ± 0.8 | 30.4 ± 2.1 |
| 6k | 4-ClPh | 39.7 ± 0.7 | 35.2 ± 2.4 | 37.0 ± 2.7 | 47.5 ± 2.4 | 31.8 ± 2.3 | 40.1 ± 1.7 | 37.2 ± 1.7 | 46.2 ± 2.5 |
| 6l | 2-ClPh | 49.3 ± 3.6 | 17.4 ± 1.6 | 33.3 ± 1.6 | 20.2 ± 0.7 | 46.2 ± 3.5 | 29.1 ± 1.8 | 15.0 ± 1.7 | 49.3 ± 1.5 |
| 6m | 2,3-diClPh | 34.7 ± 1.6 | 12.7 ± 1.1 | 17.1 ± 3.1 | 37.0 ± 1.4 | 34.5 ± 1.7 | 23.8 ± 1.6 | 14.0 ± 3.1 | 42.8 ± 1.7 |
| 6n | 2-CHOPh | 60.0 ± 2.4 | 43.9 ± 0.4 | 42.9 ± 1.6 | 65.8 ± 0.8 | 57.7 ± 2.3 | 58.2 ± 0.9 | 39.4 ± 0.8 | 55.6 ± 1.7 |
| 6o | 3-NO2Ph | 18.3 ± 0.6 | 22.5 ± 1.3 | 14.0 ± 2.8 | 44.0 ± 1.6 | 23.5 ± 4.7 | 41.0 ± 1.7 | 26.1 ± 1.4 | 52.3 ± 0.5 |
| 6p | 3-thienyl | 56.0 ± 1.2 | 27.7 ± 0.8 | 39.6 ± 4.1 | 52.3 ± 0.8 | 45.5 ± 0.3 | 47.1 ± 0.7 | 31.9 ± 2.5 | 59.4 ± 2.1 |
| 6q | 2-benzothienyl | 22.7 ± 2.7 | 24.4 ± 0.6 | 8.1 ± 2.7 | 13.2 ± 1.6 | 21.2 ± 1.3 | 16.4 ± 1.8 | 14.0 ± 2.2 | 27.5 ± 2.7 |
| 6r | 3-pyridyl | 72.0 ± 2.4 | 62.4 ± 1.6 | 47.8 ± 2.7 | 47.3 ± 0.8 | 60.1 ± 1.3 | 74.3 ± 0.5 | 70.7 ± 3.3 | 79.0 ± 2.1 |
| 6s | 4-(2-Cl-pyridyl)- | 40.5 ± 0.4 | 42.7 ± 0.8 | 46.8 ± 4.1 | 36.1 ± 1.4 | 43.9 ± 2.6 | 62.4 ± 1.2 | 38.6 ± 0.8 | 46.4 ± 1.0 |
| 7a | 4-FPhSO2NH | 50.9 ± 0.1 | 46.8 ± 1.1 | 45.1 ± 2.8 | 30.9 ± 3.5 | 44.4 ± 2.1 | 54.2 ± 0.1 | 54.4 ± 3.0 | 54.6 ± 3.2 |
| 7b | 4-OCH3PhSO2NH | 45.7 ± 0.7 | 31.7 ± 1.2 | 29.4 ± 0.2 | 37.0 ± 3.1 | 33.3 ± 1.2 | 37.3 ± 1.2 | 28.3 ± 0.1 | 27.3 ± 0.8 |
| 7c | 4-CNPhSO2NH | 32.2 ± 2.4 | 13.9 ± 2.7 | 28.5 ± 1.4 | 12.4 ± 4.4 | 32.0 ± 0.4 | 22.0 ± 2.4 | 32.6 ± 0.5 | 22.7 ± 3.2 |
| 7d | 2,4-diClPhSO2NH | 42.4 ± 1.2 | 24.1 ± 1.8 | 27.5 ± 0.1 | 24.7 ± 2.6 | 36.2 ± 1.5 | 25.4 ± 1.2 | 37.0 ± 1.5 | 18.2 ± 0.4 |
| 7e | 5-(2-Cl-pyridyl)SO2NH | 44.1 ± 1.2 | 31.7 ± 0.9 | 49.2 ± 2.8 | 12.4 ± 4.3 | 42.1 ± 0.7 | 44.1 ± 1.2 | 50.0 ± 0.7 | 31.8 ± 0.3 |
| 7f | Cl(CH2)3SO2NH | 39.0 ± 2.4 | 21.5 ± 1.8 | 29.4 ± 0.4 | 40.7 ± 1.7 | 29.0 ± 1.6 | 39.0 ± 0.6 | 32.6 ± 1.3 | 18.2 ± 0.6 |
| 8a | 4-FPhCONH | 13.6 ± 0.6 | 4.2 ± 1.1 | 2.0 ± 1.4 | 16.1 ± 2.4 | 7.2 ± 0.2 | 8.5 ± 1.2 | 7.1 ± 1.3 | 13.6 ± 0.3 |
| 8b | 4-OCF3PhCONH | 6.1 ± 0.8 | 3.4 ± 1.2 | 2.0 ± 2.8 | 1.4 ± 1.2 | 3.1 ± 2.1 | 2.1 ± 1.0 | 10.9 ± 1.5 | 9.1 ± 3.2 |
| 8c | CH3(CH2)4CONH | 8.5 ± 1.2 | 5.1 ± 1.8 | 3.9 ± 1.4 | 2.5 ± 1.6 | 1.9 ± 2.4 | 1.0 ± 0.8 | 10.9 ± 1.2 | 13.6 ± 2.1 |
| n-butylphthalide (NBP) | 76.5 ± 0.7 | 74.2 ± 0.6 | 59.4 ± 1.2 | 69.2 ± 0.2 | 13.2 ± 0.1 | 63.2 ± 0.2 | 68.0 ± 0.9 | 50.2 ± 0.3 | |
| Hymexazol | 55.9 ± 2.4 | 75.9 ± 0.9 | 39.2 ± 2.8 | 42.4 ± 2.8 | 71.4 ± 1.8 | 10.1 ± 0.4 | 68.4 ± 1.3 | 48.3 ± 2.5 | |
Although it is difficult to extract clear structure–activity relationships (SARs) from the presented biological data, the conclusion still can be summarized is that the spectrum of antifungal activity is significantly impacted by the presence of substituents. Firstly, compared with the lead compound NBP, introduction of benzene ring can enhance the activity against BC and AS (6avs NBP), and introduction of pyridine ring can increase the activity against BC, VM, SS and AS but decrease the activity against other fungi (6rvs NBP). Meanwhile, bringing chlorine atom to the compound 6r afforded the moderate potent compound 6s. Secondly, introduction of 4-OH on the benzene ring of compound 6a only significantly enhances the activity against BC strains (6evs NBP). Thirdly, for the halogenated compounds, introduction of 2-F afforded the slightly more potent compound than that of 2-Cl (6fvs6l), and monohalogenated compounds display better antifungal activity than polyhalogenated compounds against all phytopathogenic fungi at the concentration of 50 μg/mL (6fvs6i and 6j, 6mvs6k and 6l). Furthermore, it is noticeable that bearing a thiophene group at R position exhibited more pronounced antifungal effects than that of benzothiophene group (6pvs6q). Finally, compounds with sulfonylamine substitutions (7a–f) were found to have varying degree of antifungal activity. Amongst them, compound 7a with para-fluorine substitution was found to be more active than that of others. But unfortunately, compounds having the amide substitutions (8a–c) showed worse activity than aryl (6a–s) and sulfonamide substitutions (7a–f).
Meanwhile, the effects of compounds on the growth of VM and FS at the concentration of 50 μg/mL were shown in Figure 2. It can be seen clearly that the mycelium diameter was significantly smaller than that of the positive control hymexazol after treated of VM stains with tested compounds 6r, 6h, 6s, 6n and 6b. Similarly, the mycelium growth also reflected that the compound 6r had better inhibitory effects on FS strains than that of 6n, 6p, 6h, 6f and hymexazol.
Effects of compounds on the growth of Valsa mali (VM) and Fusarium sulphureum (FS) (CK: blank control group).
3 Conclusion
In summary, 28 novel n-butyphthalide derivatives were synthesized and evaluated for their antifungal activities against eight phytopathogenic fungi in vitro at the concentration of 50 μg/mL. Among all the derivatives, compounds 6a, 6f, 6n, 6r, 6s and 7a generally exhibited the promising and broad-spectrum antifungal activities, especially compound 6r displayed the more pronounced antifungal activity than the lead compound NBP and hymexazol against VM, SS and AS strains. It clearly demonstrated that introduction of appropriate substituents on the 6-position of NBP would lead to more potent derivatives. It also implied that 6r might be considered as new promising lead candidates for further design and synthesis of agricultural fungicides.
4 Experimental section
4.1 General information
All reagents and solvents were of reagent grade or purified according to standard methods before use. Thin-layer chromatography (TLC) and preparative thin-layer chromatography (PTLC) were used with silica gel 60 GF254 (Qingdao Haiyang Chemical Co., Ltd., China). Melting points (m. p.) were determined on a digital m.p. apparatus and were uncorrected. 1H NMR and 13C NMR spectra were recorded on a Bruker Avance NEO 400 and 100 MHz instruments, respectively, using TMS as the internal standard and CDCl3 or DMSO-d6 as the solvent. HRMS were carried out with an APEX II Bruker 4.7T AS instrument.
4.1.1 Synthesis of (Z)-3-butylidene-3H-isobenzofuran-1-one (1)[17]
To a mixture of phthalic anhydride (40.0 g, 270 mmol) in anhydrous THF (50 mL), n-butyllithium (100 mL, 1.0 eq, 2.7 M n-hexane solution) was added dropwise and reacted at −78 °C under N2. When the reaction was complete according to TLC analysis, the reaction was quenched with water. Subsequently, the reaction mixture was adjusted to pH 1–2 with 10% HCl and extracted with EtOAc (3 × 150 mL). The combined organic phase was washed with brine (200 mL), dried over anhydrous Na2SO4 and concentrated to give 40.0 g of a brown oily liquid. Then anhydrous toluene (150 mL) and p-toluenesulfonic acid (4.6 g, 27.0 mmol) were added and the reaction mixture was refluxed for 6 h. When the reaction was complete (TLC control), the organic solvent was removed. The crude material was purified by silica gel column chromatography to give compound 1 (16.8 g, 33.1%) as an oily liquid. 1H NMR (400 MHz, CDCl3) δ 7.89 (d, 1H, J = 8.0 Hz), 7.67–7.63 (m, 2H), 7.52 (t, 1H, J = 8.0 Hz), 5.67 (t, 1H, J = 8.0 Hz) 2.48–2.42 (m, 2H), 1.58–1.52 (m, 2H), 1.00 (t, 3H, J = 7.6 Hz, CH3); HRMS (ESI) calcd for C12H13O2 [M+H]+m/z: 189.0914, found 189.0916.
4.1.2 Synthesis of 3-n-butyl-3H-isobenzofuran-1-one (NBP, 2)
10% Palladium on carbon (800 mg) was added to a solution of compound 1 (16.0 g, 84.8 mmol) in ethanol (150 mL) under an atmosphere of hydrogen. The reaction mixture was stirred at room temperature over night and the palladium removed by filtration through Celite. The filter cake was washed with ethanol (3 × 70 mL) and the filtrates were concentrated. The residue was purified by silica gel column chromatography to give compound 2 (17.0 g, 94.5%) in yield as a colorless oily liquid. 1H NMR (400 MHz, CDCl3) δ 7.91 (d, 1H, J = 7.6 Hz), 7.67 (m, 1H), 7.54 (t, 1H, J = 7.6 Hz), 7.45 (d, 1H, J = 7.6 Hz), 5.49 (dd, 1H, J = 8.0, 4.8 Hz), 2.08–2.00 (m, 1H), 1.80–1.74 (m, 1H), 1.50–1.34 (m, 4H), 0.92 (t, 3H, J = 6.8 Hz, CH3); HRMS (ESI) calcd for C12H14O2Na [M+H]+m/z: 213.0886, found 213.0884.
4.1.3 Synthesis of 6-nitro-3-n-butylphthalide (3)[18]
To a stirred solution of the corresponding intermediates 2 (16.0 g, 75.5 mmol) in H2SO4 (30 mL) was added KNO3 (9.7 g, 95.9 mmol) at 0–5 °C. After the addition, the mixture was stirred at room temperature for 2 h. The reaction mixture was poured into ice and extracted with ethyl acetate (80 mL × 3). The combined organic layers were washed with brine (50 mL × 2), dried over anhydrous Na2SO4 and concentrated. The resulting residue was purified with column chromatography to give compound 3 (13.0 g, 73.2%) as light yellow liquid. 1H NMR (400 MHz, CDCl3) δ 8.72 (d, 1H, J = 2.0 Hz), 8.57 (dd, 1H, J = 8.4, 2.0 Hz), 7.68 (d, 1H, J = 8.4 Hz), 5.62–5.59 (m, 1H), 2.16–2.08 (m, 1H), 1.87–1.78 (m, 1H), 1.45–1.36 (m, 4H), 0.94 (t, 3H, J = 6.8 Hz, CH3); 13C NMR (100 MHz, CDCl3) δ 168.0, 155.3, 149.0, 128.8, 127.9, 123.2, 121.3, 81.5, 34.1, 26.8, 22.3, 13.7.
4.1.4 Synthesis of 3-butyl-6-amino-1(3H)-isobenzofuranone (4)
To a stirred solution of the intermediate 3 (12.0 g, 51.0 mmol) in THF/H2O (60 mL/15 mL) was added iron powder (28.4 g, 0.51 mol) and NH4Cl (2.05 g, 38.3 mmol). Then, the mixture was heated to reflux for 5 h under an argon atmosphere. After complete reaction, the mixture was filtered and the filtrate was concentrated. The resulting residue was purified by column chromatography to afford the compound 4 (9.5 g, 90.9%) as a white solid. m.p. 118–120 °C; 1H NMR (400 MHz, CDCl3) δ 7.19 (d, 1H, J = 8.0 Hz), 7.10 (d, 1H, J = 2.0 Hz), 6.97 (dd, 1H, J = 8.4, 2.4 Hz), 5.38–5.35 (m, 1H),3.95 (s, 2H, NH2), 1.99–1.92 (m, 1H), 1.74–1.66 (m, 1H), 1.47–1.32 (m, 4H), 0.91 (t, 3H, J = 6.8 Hz, CH3); 13C NMR (100 MHz, CDCl3) δ 171.0, 147.5, 140.1, 127.4, 122.3, 121.4, 109.7, 81.4, 34.7, 26.8, 22.4, 13.8. HRMS (ESI) calcd. for C12H16NO2 [M+H]+m/z: 206.1181, found 206.1184.
4.1.5 Synthesis of 3-butyl-6-bromo-1(3H)-isobenzofuranone (5)
A mixture of 6-amino-3-n-butylphthalide 4 (6.0 g, 29.25 mmol) in 48% HBr (5 mL) and H2O (5 mL) in a three-neck flask was cooled in an ice bath. A solution of NaNO2 (2.13 g, 30.9 mmol) in H2O (30 mL) was added slowly and stirred at 0 °C for 40 min. Then, this mixture of CuBr (4.4 g, 30.7 mmol) and 48% HBr (37.5 mL) was slowly added into the diazonium solution. When the addition was complete, the solution was stirred at 80 °C for 2 h and room temperature for 12 h. The reaction mixture was extracted with AcOEt (60 mL × 3), and the organic layer was washed with brine (50 mL) and dried over anhydrous Na2SO4. Removal of solvent followed by column chromatographic purification afforded 5 as a white solid (4.5 g, 57.4%). m.p. 68–70 °C; 1H NMR (400 MHz, CDCl3) δ 8.02 (d, 1H, J = 1.6 Hz), 7.79 (dd, 1H, J = 8.0, 1.6 Hz), 7.33 (d, 1H, J = 8.0 Hz), 5.45–5.42 (m, 1H), 2.07–1.98 (m, 1H), 1.80–1.71 (m, 1H), 1.48–1.33 (m, 4H), 0.92 (t, 3H, J = 6.8 Hz, CH3); 13C NMR (100 MHz, CDCl3) δ 169.0, 148.7, 136.9, 128.7, 128.3, 123.3, 122.9, 81.3, 34.2, 26.7, 22.3, 13.8; HRMS (ESI) calcd for C12H14BrO2 [M+H]+m/z: 269.0177, found 269.0176.
4.2 The general procedures for synthesis of compounds 6a–s
In a 25 mL round-bottom flask containing dioxane/H2O (V:V = 5:1) (3 mL), K2CO3 (207 mg, 1.5 mmol), 3-butyl-6-bromo-1(3H)-isobenzofuranone (135 mg, 0.5 mmol), substituted boronic acid (0.65 mmol) and Pd(PPh3)4 (29 mg, 0.025 mmol) were added and reacted at 90 °C under N2. When the reaction was complete (TLC control), the organic solvent was removed. The crude material was then purified by silica gel column chromatography to give desired products 6a–s, which were characterized by m. p., 1H NMR, 13C NMR and HR-MS.
4.2.1 3-Butyl-6-phenylisobenzofuran-1(3H)-one (6a)
Yield: 95%, colorless oily liquid. 1H NMR (400 MHz, CDCl3) δ 8.09 (d, J = 1.6 Hz, 1H), 7.90 (dd, J = 8.0, 1.6 Hz, 1H), 7.62–7.59 (m, 2H), 7.51–7.46 (m, 3H), 7.42–7.38 (m, 1H), 5.52–5.50 (m, 1H), 2.10–2.03 (m, 1H), 1.85–1.76 (m, 1H), 1.54–1.36 (m, 4H), 0.94 (t, J = 7.2 Hz, 3H); 13C NMR (100 MHz, CDCl3) δ 170.6, 148.8, 142.6, 139.4, 133.0, 129.0, 128.1, 127.2, 126.9, 123.9, 122.1, 81.4, 34.5, 26.9, 22.4, 13.8; HRMS (ESI) calcd for C18H19O2 [M + H]+m/z: 267.1385, found 267.1386.
4.2.2 3-Butyl-6-p-tolylisobenzofuran-1(3H)-one (6b)
Yield: 56%, colorless oily liquid. 1H NMR (400 MHz, DMSO-d6) δ 8.06 (d, J = 8.0 Hz, 1H), 8.00 (s, 1H), 7.75 (d, J = 8.0 Hz, 1H), 7.66 (d, J = 8.0 Hz, 2H), 7.31 (d, J = 8.0 Hz, 2H), 5.68–5.65 (m, 1H), 2.36 (s, 3H), 2.12–2.05 (m, 1H), 1.77–1.68 (m, 1H), 1.41–1.27 (m, 4H), 0.89 (t, J = 6.8 Hz, 3H); 13C NMR (100 MHz, DMSO-d6) δ 170.2, 149.3, 141.8, 138.0, 136.3, 133.2, 130.1, 127.3, 126.6, 123.6, 122.6, 81.5, 33.9, 26.9, 22.3, 21.1, 14.2; HRMS (ESI) calcd for C19H21O2 [M+H]+m/z: 281.1542, found 281.1543.
4.2.3 3-Butyl-6-(4-ethylphenyl)isobenzofuran-1(3H)-one (6c)
Yield: 63%, colorless oily liquid. 1H NMR (400 MHz, CDCl3) δ 8.08 (s, 1H), 7.89 (dd, J = 8.0, 1.6 Hz, 1H), 7.54 (d, J = 8.0 Hz, 2H), 7.48 (d, J = 8.0 Hz, 1H), 7.32 (d, J = 7.6 Hz, 2H), 5.52–5.49 (m, 1H), 2.74 (q, J = 7.6 Hz, 2H), 2.10–2.02 (m, 1H), 1.85–1.75 (m, 1H), 1.52–1.36 (m, 4H), 1.30 (t, J = 7.6 Hz, 3H), 0.94 (t, J = 7.6 Hz, 3H); 13C NMR (100 MHz, CDCl3) δ 170.7, 148.6, 144.4, 142.6, 136.8, 132.9, 128.6, 127.1, 126.9, 123.7, 122.0, 81.4, 34.5, 28.5, 26.9, 22.4, 15.5, 13.8; HRMS (ESI) calcd for C20H23O2 [M+H]+m/z: 295.1698, found 295.1696.
4.2.4 6-(4-Aminophenyl)-3-butylisobenzofuran-1(3H)-one (6d)
Yield: 81%, light yellow solid, m. p. 145–146 °C. 1H NMR (400 MHz, CDCl3) δ 8.01 (s, 1H), 7.83 (dd, J = 8.0, 1.6 Hz, 1H), 7.44–7.41 (m, 3H), 6.78 (d, J = 8.4 Hz, 2H), 5.50–5.47 (m, 1H), 3.71 (br, 2H, NH2), 2.08–2.01 (m, 1H), 1.82–1.74 (m, 1H), 1.53–1.35 (m, 4H), 0.93 (t, J = 7.2 Hz, 3H); 13C NMR (100 MHz, CDCl3) δ 170.9, 147.8, 146.6, 142.5, 132.2, 129.5, 128.1, 126.8, 122.8, 121.9, 115.4, 81.4, 34.5, 26.9, 22.4, 13.8; HRMS (ESI) calcd for C18H20NO2 [M+H]+m/z: 282.1494, found 282.1496.
4.2.5 3-Butyl-6-(4-hydroxyphenyl)isobenzofuran-1(3H)-one (6e)
Yield: 69%, white acicular solid, m. p. 194–195 °C. 1H NMR (400 MHz, CDCl3) δ 8.04 (s, 1H), 7.85 (dd, J = 8.0, 1.6 Hz, 1H), 7.50 (d, J = 8.8 Hz, 1H), 7.47 (d, J = 8.0 Hz, 2H), 6.96 (d, J = 8.4 Hz, 2H), 5.53–5.50 (m, 1H), 2.09–2.02 (m, 1H), 1.84–1.75 (m, 1H), 1.54–1.36 (m, 4H), 0.94 (t, J = 7.6 Hz, 3H); 13C NMR (100 MHz, CDCl3) δ 170.9, 155.9, 148.3, 142.2, 132.6, 128.5, 126.8, 123.3, 122.0, 116.1, 116.0, 81.5, 34.5, 26.9, 22.4, 13.8; HRMS (ESI) calcd for C18H19O3 [M+H]+m/z: 283.1334, found 283.1336.
4.2.6 3-Butyl-6-(2-fluorophenyl)isobenzofuran-1(3H)-one (6f)
Yield: 55%, white solid, m. p. 59–61 °C. 1H NMR (400 MHz, DMSO-d6) δ 7.97 (d, J = 8.0 Hz, 1H), 7.94 (s, 1H), 7.81 (d, J = 8.0 Hz, 1H), 7.65 (t, J = 8.0 Hz, 1H), 7.50–7.46 (m, 1H), 7.39–7.33 (m, 2H), 5.72–5.69 (m, 1H), 2.15–2.07 (m, 1H), 1.79–1.70 (m, 1H), 1.43–1.30 (m, 4H) , 0.90 (t, J = 6.8 Hz, 3H); 13C NMR (100 MHz, DMSO-d6) δ 170.0, 160.7, 158.3, 150.0, 136.5, 135.4, 131.4, 130.8, 127.3, 126.3, 125.6, 123.4, 116.7, 81.6, 33.9, 27.0, 22.3, 14.2; HRMS (ESI) calcd for C18H18FO2 [M+H]+m/z: 285.1291, found 285.1294.
4.2.7 3-Butyl-6-(2-fluoro-4-methoxyphenyl)isobenzofuran-1(3H)-one (6g)
Yield: 77%, colorless oily liquid. 1H NMR (400 MHz, CDCl3) δ 8.00 (s, 1H), 7.83–7.80 (m, 1H), 7.48 (d, J = 8.0 Hz, 1H), 7.39 (t, J = 8.8 Hz, 1H), 6.82 (dd, J = 8.4, 2.4 Hz, 1H), 6.76 (dd, J = 8.4, 2.4 Hz, 1H), 5.52–5.49 (m, 1H), 3.85 (s, 3H, OCH3), 2.11–2.02 (m, 1H), 1.84–1.75 (m, 1H), 1.52–1.36 (m, 4H), 0.94 (t, J = 7.2 Hz, 3H); 13C NMR (100 MHz, CDCl3) δ 170.5, 161.5, 159.0, 148.7, 137.0, 134.6, 130.9, 126.6, 125.5, 121.7, 119.7, 110.6, 102.3, 81.4, 55.6, 34.5, 26.9, 13.8; HRMS (ESI) calcd for C19H20FO3 [M+H]+m/z: 315.1396, found 315.1397.
4.2.8 4-(1-Butyl-3-oxo-1,3-dihydroisobenzofuran-5-yl)-3-fluorobenzaldehyde (6h)
Yield: 77%, colorless oily liquid. 1H NMR (400 MHz, CDCl3) δ 10.42 (s, 1H, CHO), 8.13 (s, 1H), 8.02–7.98 (m, 1H), 7.94 (dd, J = 8.0, 2.0 Hz, 1H), 7.60 (d, J = 7.6 Hz, 1H), 7.56 (d, J = 8.0 Hz, 1H), 7.46 (d, J = 7.2 Hz, 1H), 5.58–5.55 (m, 1H), 2.15–2.05 (m, 1H), 1.88–1.79 (m, 1H), 1.55–1.38 (m, 4H), 0.96 (t, J = 7.2 Hz, 3H); 13C NMR (100 MHz, CDCl3) δ 186.6, 170.0, 166.2, 163.6, 150.4, 147.6, 139.9, 132.9, 129.5, 127.4, 124.2, 123.4, 122.6, 115.2, 81.4, 34.3, 26.8, 22.4, 13.8; HRMS (ESI) calcd for C19H18FO3 [M+H]+m/z: 313.1240, found 313.1343.
4.2.9 3-Butyl-6-(3-(trifluoromethyl)phenyl)isobenzofuran-1(3H)-one (6i)
Yield: 86%, white solid, m. p. 86–87 °C. 1H NMR (400 MHz, DMSO-d6) δ 8.18–8.16 (m, 2H), 8.10–8.09 (d, 2H), 7.82–7.72 (m, 3H), 5.72–5.69 (m, 1H), 2.15–2.08 (m, 1H), 1.76–1.70 (m, 1H), 1.38–1.32 (m, 4H), 0.90 (t, J = 7.2 Hz, 3H); 13C NMR (100 MHz, DMSO-d6) δ 170.0, 150.3, 140.2, 133.8, 131.7, 130.6, 130.5, 130.2, 126.8, 125.9, 125.1, 124.1, 123.8, 123.6, 81.5, 33.9, 26.9, 22.3, 14.2; HRMS (ESI) calcd for C19H18F3O2 [M+H]+m/z: 335.1259, found 335.1262.
4.2.10 3-Butyl-6-(4-(trifluoromethoxy)phenyl)isobenzofuran-1(3H)-one (6j)
Yield: 86%, white solid, m. p. 68–69 °C. 1H NMR (400 MHz, CDCl3) δ 8.06 (s, 1H), 7.87 (dd, J = 8.0, 1.6 Hz, 1H), 7.63 (d, J = 8.8 Hz, 2H), 7.53 (d, J = 8.0 Hz, 1H), 7.34 (d, J = 8.4 Hz, 2H), 5.54–5.51 (m, 1H), 2.11–2.04 (m, 1H), 1.85–1.76 (m, 1H), 1.52–1.38 (m, 4H), 0.94 (t, J = 7.4 Hz, 3H); 13C NMR (100 MHz, CDCl3) δ 170.4, 149.2, 141.2, 138.2, 132.9, 128.6, 127.1, 123.9, 122.3, 121.7, 121.5, 119.2, 81.4, 34.4, 26.9, 22.4, 13.8; HRMS (ESI) calcd for C19H18F3O3 [M+H]+m/z: 351.1208, found 351.1209.
4.2.11 3-Butyl-6-(4-chlorophenyl)isobenzofuran-1(3H)-one (6k)
Yield: 87%, white solid, m. p. 63–64 °C. 1H NMR (400 MHz, CDCl3) δ 8.05 (s, 1H), 7.86 (dd, J = 8.0, 1.6 Hz, 1H), 7.55 (d, J = 8.8 Hz, 2H), 7.51 (d, J = 7.6 Hz, 1H), 7.46 (d, J = 8.4 Hz, 2H), 5.53–5.50 (m, 1H), 2.10–2.03 (m, 1H), 1.84–1.76 (m, 1H), 1.50–1.36 (m, 4H), 0.94 (t, J = 7.2 Hz, 3H); 13C NMR (100 MHz, CDCl3) δ 168.6, 147.3, 139.6, 136.1, 132.6, 131.0, 127.4, 126.6, 125.3, 122.0, 120.4, 79.6, 32.6, 25.0, 20.6, 12.0; HRMS (ESI) calcd for C18H18ClO2 [M+H]+m/z: 301.0995, found 301.0997.
4.2.12 3-Butyl-6-(2-chlorophenyl)isobenzofuran-1(3H)-one (6l)
Yield: 38%, light yellow solid, m. p. 96–97 °C. 1H NMR (400 MHz, DMSO-d6) δ 7.86–7.78 (m, 3H), 7.62–7.60 (m, 1H), 7.51–7.45 (m, 3H), 5.72–5.69 (m, 1H), 2.16–2.08 (m, 1H), 1.79–1.70 (m, 1H), 1.45–1.32 (m, 4H), 0.90 (t, J = 7.2 Hz, 3H); 13C NMR (100 MHz, DMSO-d6) δ 170.0, 150.0, 140.1, 138.8, 135.9, 132.1, 131.7, 130.4, 130.3, 128.2, 125.9, 125.7, 123.1, 81.6, 33.9, 27.1, 22.3, 14.2; HRMS (ESI) calcd for C18H18ClO2 [M+H]+m/z: 301.0995, found 301.0998.
4.2.13 3-Butyl-6-(2,3-dichlorophenyl)isobenzofuran-1(3H)-one (6m)
Yield: 90%, white solid, m.p. 57-58 oC. 1H NMR (400 MHz, DMSO-d6) δ 7.86-7.83 (m, 2H), 7.81 (s, 1H), 7.73 (dd, J = 7.2, 2.4 Hz, 1H), 7.50-7.45 (m, 2H), 5.73-5.70 (m, 1H), 2.16- 2.08 (m, 1H), 1.79-1.70 (m, 1H), 1.46-1.31 (m, 4H), 0.91 (t, J = 7.2 Hz, 3H); 13C NMR (100 MHz, DMSO-d6) δ 169.9, 150.4, 141.3, 139.9, 135.8, 132.8, 130.7, 130.2, 128.9, 126.0, 125.7, 123.1, 81.7, 33.9, 27.1, 22.3, 14.2; HRMS (ESI) calcd for C18H17Cl2O2 [M+H]+ m/z: 335.0606, found 335.0607.
4.2.14 3-(1-Butyl-3-oxo-1,3-dihydroisobenzofuran-5-yl)benzaldehyde (6n)
Yield: 82%, white solid, m.p. 76–75 °C. 1H NMR (400 MHz, CDCl3) δ 9.96 (s, 1H, CHO), 8.06 (dd, J = 7.6, 1.2 Hz, 1H), 7.93 (s, 1H), 7.71–7.65 (m, 2H), 7.59–7.53 (m, 2H), 7.45–7.43 (m, 1H), 5.58–5.55 (m, 1H), 2.13–2.06 (m, 1H), 1.87–1.79 (m, 1H), 1.56–1.38 (m, 4H), 0.96 (t, J = 7.2 Hz, 3H); 13C NMR (100 MHz, CDCl3) δ 191.4, 170.0, 149.7, 143.7, 139.3, 135.8, 133.9, 133.6, 130.9, 128.6, 128.5, 126.8, 126.5, 121.7, 81.4, 34.48, 26.9, 22.4, 13.8; HRMS (ESI) calcd for C19H19O3 [M+H]+m/z: 395.1334, found 395.1337.
4.2.15 3-Butyl-6-(3-nitrophenyl)isobenzofuran-1(3H)-one (6o)
Yield: 71%, white solid, m. p. 96–97 °C. 1H NMR (400 MHz, CDCl3) δ 8.49 (s, 1H), 8.28–8.26 (m, 1H), 8.13 (s, 1H), 7.96–7.93 (m, 2H), 7.70 (t, J = 8.0 Hz, 1H), 7.59 (d, J = 8.0 Hz, 1H), 5.58–5.55 (m, 1H), 2.13–2.06 (m, 1H), 1.87–1.78 (m, 1H), 1.55–1.37 (m, 4H), 0.95 (t, J = 7.2 Hz, 3H); 13C NMR (100 MHz, CDCl3) δ 170.1, 150.0, 148.8, 141.1, 140.1, 133.1, 132.9, 130.1, 127.4, 124.1, 122.9, 122.7, 122.1, 81.5, 34.4, 26.8, 22.4, 13.8; HRMS (ESI) calcd for C18H18NO4 [M+H]+m/z: 312.1236, found 312.1239.
4.2.16 3-Butyl-6-(thiophen-3-yl)isobenzofuran-1(3H)-one (6p)
Yield: 98%, colorless oily liquid. 1H NMR (400 MHz, CDCl3) δ 8.08 (d, J = 0.8 Hz, 1H), 7.90 (d, J = 8.0, 1.6 Hz, 1H), 7.54–7.53 (m, 1H), 7.46–7.41 (m, 3H), 5.51–5.48 (m, 1H), 2.09–2.02 (m, 1H), 1.83–1.74 (m, 1H), 1.51–1.33 (m, 4H), 0.93 (t, J = 7.2 Hz, 3H); 13C NMR (100 MHz, CDCl3) δ 170.6, 148.6, 140.5, 137.15, 132.2, 126.9, 126.1, 123.0, 122.1, 121.5, 81.4, 34.4, 26.8, 22.4, 13.8; HRMS (ESI) calcd for C16H17O2S [M+H]+m/z: 273.0949, found 273.0951.
4.2.17 6-(Benzo[b]thiophen-2-yl)-3-butylisobenzofuran-1(3H)-one (6q)
Yield: 71%, white solid, m. p. 114–115 °C. 1H NMR (400 MHz, CDCl3) δ 8.20 (d, J = 1.2 Hz, 1H), 8.00 (dd, J = 8.0, 1.6 Hz, 1H), 7.85 (d, J = 8.8 Hz,1H), 7.81 (dd, J = 7.2, 1.6 Hz, 1H), 7.62 (s, 1H), 7.48 (d, J = 8.4 Hz, 1H), 7.39–7.33 (m, 2H), 5.52–5.49 (m, 1H), 2.09–2.02 (m, 1H), 1.84–1.75 (m, 1H), 1.53–1.36 (m, 4H), 0.94 (t, J = 7.2 Hz, 3H); 13C NMR (100 MHz, CDCl3) δ 170.2, 149.5, 142.1, 140.4, 139.6, 135.7, 132.1, 127.2, 124.9, 124.8, 123.9, 123.1, 122.3, 120.8, 81.5, 34.4, 26.8, 22.4, 13.8; HRMS (ESI) calcd for C20H19O2S [M+H]+m/z: 323.1106, found 323.1107.
4.2.18 3-Butyl-6-(pyridin-3-yl)isobenzofuran-1(3H)-one (6r)
Yield: 35%, colorless oily liquid. 1H NMR (400 MHz, CDCl3) δ 8.88 (d, J = 1.6 Hz, 1H), 8.67 (dd, J = 4.8, 1.6 Hz, 1H), 8.09 (d, J = 1.2 Hz,1H), 7.93–7.88 (m, 2H), 7.57 (d, J = 8.0 Hz, 1H), 7.45–7.41 (m, 1H), 5.56–7.53 (m, 1H), 2.13–2.05 (m, 1H), 1.87–1.77 (m, 1H), 1.51–1.37 (m, 4H), 0.94 (t, J = 7.2 Hz, 3H); 13C NMR (100 MHz, CDCl3) δ 170.2, 149.7, 149.2, 148.2, 139.2, 135.1, 134.6, 132.9, 127.3, 124.1, 123.8, 122.5, 81.4, 34.4, 26.8, 22.4, 13.8; HRMS (ESI) calcd for C17H18NO2 [M+H]+m/z: 268.1338, found 268.1340.
4.2.19 3-Butyl-6-(2-chloropyridin-4-yl)isobenzofuran-1(3H)-one (6s)
Yield: 60%, colorless oily liquid. 1H NMR (400 MHz, CDCl3) δ 8.50 (d, J = 5.2 Hz, 1H), 8.13 (d, J = 1.6 Hz, 1H), 7.92 (dd, J = 8.0, 2.0 Hz, 1H), 7.60 (d, J = 8.0 Hz, 1H), 7.58 (s, 1H), 7.47 (dd, J = 5.2, 1.6 Hz, 1H), 5.57–5.54 (m, 1H), 2.14–2.04 (m, 1H), 1.88–1.77 (m, 1H), 1.54–1.36 (m, 4H), 0.94 (t, J = 7.2 Hz, 3H); 13C NMR (100 MHz, CDCl3) δ 169.8, 152.5, 151.0, 150.3, 149.8, 138.3, 132.7, 127.5, 124.2, 122.8, 122.2, 120.5, 81.4, 34.3, 26.8, 22.4, 13.8; HRMS (ESI) calcd for C17H17ClNO2 [M+H]+m/z: 302.0948, found 302.0950.
4.3 The general procedures for synthesis of compounds 7a–f and 8a–d
A solution of compound 4 (0.4 mmol) and the corresponding R1SO2Cl or R2COCl (0.18 mmol) in pyridine (1.5 mL) was stirred at room temperature. When the reaction was complete, as checked by TLC analysis, the solution of the mixture was diluted with AcOEt (30 mL). Subsequently, the solution was washed with water (15 mL), 0.1 N aqueous HCl (25 mL) and brine (25 mL), dried over anhydrous Na2SO4, concentrated in vacuo, and purified by silica gel column chromatography to give the target products 7a–f and 8a–d, which were characterized by m. p., 1H NMR, 13CNMR and HRMS.
4.3.1 N-(1-butyl-3-oxo-1,3-dihydroisobenzofuran-5-yl)-4-fluorobenzenesulfonamide (7a)
Yield 75.7%, white solid, m. p. 112–113 °C. 1H NMR (400 MHz, CDCl3) δ 7.85–7.82 (m, 2H), 7.54–7.52 (m, 2H), 7.421 (s, 1H), 7.36 (d, J = 8.8 Hz, 1H), 7.15 (t, J = 8.4 Hz, 2H), 5.43–5.40 (m, 1H), 2.05–1.95 (m, 1H), 1.75–1.67 (m, 1H), 1.47–1.31 (m, 4H), 0.91 (t, J = 7.2 Hz, 3H); 13C NMR (100 MHz, CDCl3) δ 169.9, 166.7, 164.1, 146.8, 137.6, 134.6, 130.0, 127.5, 122.9, 117.5, 116.7, 116.5, 81.5, 34.3, 26.8, 22.3, 13.8; HRMS (ESI) calcd for C18H19FNO4S [M+H]+m/z: 364.1019, found 364.1020.
4.3.2 N-(1-Butyl-3-oxo-1,3-dihydroisobenzofuran-5-yl)-4-methoxybenzenesulfonamide (7b)
Yield 80.0%, white solid, m. p. 153–154 °C; 1H NMR (400 MHz, CDCl3) δ 7.76 (d, J = 8.8 Hz, 2H), 7.53–7.51 (m, 2H), 7.34–7.31 (m, 2H), 6.92 (d, J = 9.2 Hz, 2H), 5.41–5.38 (m, 1H), 3.83 (s, 3H), 2.01–1.94 (m, 1H), 1.74–1.66 (m, 1H), 1.46–1.31 (m, 4H), 0.90 (t, J = 7.2 Hz, 3H); 13C NMR (100 MHz, CDCl3) δ 169.9, 163.4, 146.4, 138.1, 130.0, 129.4, 127.3, 122.8, 117.1, 114.4, 81.4, 55.6, 34.3, 26.8, 22.3, 13.8; HRMS (ESI) calcd for C19H22NO5S [M+H]+m/z: 376.1219, found 376.1221.
4.3.3 N-(1-butyl-3-oxo-1,3-dihydroisobenzofuran-5-yl)-4-cyanobenzenesulfonamide (7c)
Yield 84.7%, white solid, m. p. 160–162 °C; 1H NMR (400 MHz, CDCl3) δ 7.93 (d, J = 8.0 Hz, 2H), 7.78 (d, J = 8.2 Hz, 2H), 7.54–7.52 (m, 2H), 7.39–7.33 (m, 2H), 5.45–5.42 (m, 1H), 2.03–1.97 (m, 1H), 1.76–1.67 (m, 1H), 1.46–1.34 (m, 4H), 0.92 (t, J = 7.2 Hz, 3H); 13C NMR (100 MHz, CDCl3) δ 169.7, 147.3, 142.9, 137.0, 133.1, 127.8, 123.1, 117.9, 117.2, 116.9, 81.5, 34.3, 26.9, 22.3, 13.8; HRMS (ESI) calcd for C19H19N2O4S [M+H]+m/z: 371.1066, found 371.1069.
4.3.4 N-(1-butyl-3-oxo-1,3-dihydroisobenzofuran-5-yl)-2,4-dichlorobenzenesulfonamide (7d)
Yield 59.9%, yellow oil, 1H NMR (400 MHz, CDCl3) δ 7.99 (d, J = 8.2 Hz, 1H), 7.65 (s, 1H), 7.59 (d, J = 2.0 Hz, 1H), 7.54–7.51 (m, 2H), 7.35–7.32 (m, 2H), 5.40–5.37 (m, 1H), 2.01–1.92 (m, 1H), 1.72–1.64 (m, 1H), 1.46–1.30 (m, 4H), 0.90 (t, J = 7.2 Hz, 3H); 13C NMR (100 MHz, CDCl3) δ 169.7, 147.0 140.4, 136.9, 134.4, 132.9, 132.4, 131.7, 127.7, 127.5, 127.2, 123.0, 117.3, 81.4, 34.3, 26.9, 22.3, 13.8; HRMS (ESI) calcd for C18H18Cl2NO4S [M+H]+m/z: 415.0334, found 415.0336.
4.3.5 N-(1-butyl-3-oxo-1,3-dihydroisobenzofuran-5-yl)-6-chloropyridine-3-sulfonamide (7e)
Yield 84.1%, white solid, m. p. 140–142 °C; 1H NMR (400 MHz, CDCl3) δ 8.76 (d, J = 2.4 Hz, 1H), 8.06 (dd, J = 8.4, 2.8 Hz, 1H), 7.89 (s, 1H), 7.62–7.60 (m, 2H), 7.45 (d, J = 8.4 Hz, 1H), 7.41 (d, J = 8.0 Hz, 1H), 5.46–5.43 (m, 1H), 2.05–1.96 (m, 1H), 1.78–1.69 (m, 1 H), 1.47–1.33 (m, 4H), 0.92 (t, J = 7.2 Hz, 3H); 13C NMR (100 MHz, CDCl3) δ 170.1, 156.1, 148.4, 147.4, 137.4, 137.1, 134.5, 127.8, 127.5, 124.9, 123.2, 118.0, 81.8, 34.3, 26.9, 22.3, 13.8; HRMS (ESI) calcd for C17H18ClN2O4S [M+H]+m/z: 381.0676, found 381.0678.
4.3.6 N-(1-butyl-3-oxo-1,3-dihydroisobenzofuran-5-yl)-3-chloropropane-1-sulfonamide (7f)
Yield 84.7%, white solid, m. p. 100–101 °C; 1H NMR (400 MHz, CDCl3) δ 7.74 (d, J = 1.6 Hz, 1H), 7.64 (dd, J = 8.0, 2.0 Hz, 1H), 7.48 (s, 1H), 7.44 (d, J = 8.0 Hz, 1H), 5.49–5.46 (m, 1H), 3.68 (t, J = 6.0 Hz, 2H), 3.36 (t, J = 7.2 Hz, 2H), 2.36–2.30 (m, 2H), 2.06–1.99 (m, 1H), 1.81–1.72 (m, 1H), 1.50–1.34 (m, 4H), 0.93 (t, J = 7.2 Hz, 3H); 13C NMR (100 MHz, CDCl3) δ 170.2, 146.5, 138.1, 127.6, 126.7, 123.2, 116.6, 81.7, 49.5, 42.5, 34.3, 26.8, 26.6, 22.4, 13.8; HRMS (ESI) calcd for C15H21ClNO4S [M+H]+m/z: 346.0880, found 346.0881.
4.3.7 N-(1-butyl-3-oxo-1,3-dihydroisobenzofuran-5-yl)-4-fluorobenzamide (8a)
Yield 76.4 %, white solid, m. p. 210–211 °C; 1H NMR (400 MHz, DMSO-d6) δ 10.58 (s, 1H, NH), 8.31 (d, J = 1.6 Hz, 1H), 8.08–8.05 (m, 3H), 7.67 (d, J = 8.4 Hz, 1H), 7.42 (t, J = 8.8 Hz, 2H), 5.63–5.61 (m, 1H), 2.08–2.01 (m, 1H), 1.74–1.68 (m, 1H), 1.40–1.23 (m, 4H), 0.89 (t, J = 7.2 Hz, 3H); 13C NMR (100 MHz, DMSO-d6) δ 170.3, 165.2, 145.6, 140.4, 131.0, 130.9, 126.91, 126.3, 123.3, 116.0, 115.87, 115.82, 81.5, 34.0, 26.8, 22.3, 14.2; HRMS (ESI) calcd for C19H19FNO3 [M+H]+m/z: 328.1349, found 328.1350.
4.3.8 N-(1-butyl-3-oxo-1,3-dihydroisobenzofuran-5-yl)-3-(trifluoromethoxy)benzamide (8b)
Yield 74.6%, white solid, m. p. 200–202 °C; 1H NMR (400 MHz, CDCl3) δ 8.79 (s, 1H, NH), 8.43 (d, J = 8.0 Hz, 1H), 8.13 (s, 1H), 7.98 (d, J = 7.6 Hz, 1H), 7.91 (s, 1H), 7.58 (t, J = 8.0 Hz, 1H), 7.47–7.42 (m, 2H), 5.51–5.49 (m, 1H), 2.07–2.01 (m, 1H), 1.81–1.73 (m, 1H), 1.50–1.34 (m, 4H), 0.93 (t, J = 7.2 Hz, 3H); 13C NMR (100 MHz, CDCl3) δ 170.8, 164.4, 149.5, 145.8, 139.2, 136.2, 130.3, 126.8, 126.7, 125.5, 124.5, 122.5, 120.4, 116.7, 81.9, 34.4, 26.8, 22.4, 13.8; HRMS (ESI) calcd for C20H19F3NO4 [M+H]+m/z: 394.1266, found 394.1267.
4.3.9 N-(1-butyl-3-oxo-1,3-dihydroisobenzofuran-5-yl)hexanamide (8d)
Yield 65.9%, white solid, m. p. 132–134 °C; 1H NMR (400 MHz, CDCl3) δ 8.23 (d, J = 8.0 Hz, 1H), 8.07 (s, 1H, NH), 7.88 (d, J = 1.6 Hz, 1H), 7.39 (d, J = 8.4 Hz, 1H), 5.47–5.44 (m, 1H), 2.45 (t, J = 7.6 Hz, 2H), 2.05–1.98 (m, 1H), 1.78–1.71 (m, 3H), 1.47–1.31 (m, 8H), 0.92–0.88 (m, 6H); 13C NMR (100 MHz, CDCl3) δ 172.1, 170.7, 145.2, 139.5, 126.6, 126.2, 122.3, 115.8, 81.7, 37.6, 34.4, 31.4, 26.8, 25.2, 22.4, 13.9, 13.8; HRMS (ESI) calcd for C18H26NO3 [M+H]+m/z: 304.1913, found 304.1917.
4.4 Biological assay
The synthesized compounds were screened in vitro for their antifungal activities against eight phytopathogenic fungi by poisoned food technique. Eight phytopathogenic fungi such as FS, T. cucumeris (TC), F. oxysporum (FO), F. graminearum (FG), B. cinerea (BC), B. cinerea Per.et Fries (BP), V. mali (VM), S. sclerotiorum (SS) and A. solani (AS) were used for the assays. Potato dextrose agar (PDA) medium was prepared in the flasks and sterilized. The synthesized compounds were dissolved in acetone before mixing with PDA, and the concentration of test compounds in the medium was fixed at 50 μg/mL. The medium was then poured into sterilized Petri dishes. All types of fungi were incubated in PDA at 27 ± 0.5 °C for 5 days to get new mycelium for the antifungal assays, and a mycelia disk of approximately 4 mm diameter cut from culture medium was picked up with a sterilized inoculation needle and inoculated in the center of the PDA Petri dishes. The inoculated Petri dishes were incubated at 27 ± 0.5 °C for 4 days. Acetone without any compounds mixed with PDA served as a control, while hymexazol, a commercial agricultural fungicide, was used as positive control. For each treatment, three replicates were conducted. The radial growths of the fungal colonies were measured and the data were statistically analyzed. The inhibitory effects of the test compounds on these fungi in vitro were calculated by the formula: Inhibition rate (%) = (C−T) × 100/(C−4 mm), where C represents the diameter of fungi growth on untreated PDA, and T represents the diameter of fungi on treated PDA. Statistical analysis was processed by the SPSS 21.0 (SPSS Inc., Chicago, USA) software.
Funding source: Guizhou Provincial Engineering Laboratory for Chemical Drug R&D
Award Identifier / Grant number: [2016]5402
Funding source: Guizhou Provincial Natural Science Foundation
Award Identifier / Grant number: [2016]2848, [2017]2835, [2019]1269 and [2020]1Y11
Funding source: the Project of Postgraduate Scientific Research Fund of Guizhou
Award Identifier / Grant number: YJSCXJH[2019]077
Funding source: National University Students Innovation and Entrepreneurship Training Program
Award Identifier / Grant number: 20195200120
Funding source: The Opening Foundation of The Key Laboratory of Green Pesticide and Agricultural Bioengineering, Ministry of Education, Guizhou University
Award Identifier / Grant number: 2018GDGP0101
Funding source: National Natural Science Foundation of Guizhou Medical University
Award Identifier / Grant number: 19NSP075
Acknowledgments
This research was supported by the Guizhou Provincial Engineering Laboratory for Chemical Drug R&D (No. [2016]5402), Guizhou Provincial Natural Science Foundation (No. [2016]2848, [2017]2835, [2019]1269 and [2020]1Y111), The Project of Postgraduate Scientific Research Fund of Guizhou (No. YJSCXJH[2019]077), National University Students Innovation and Entrepreneurship Training Program (No. 20195200120) and The Opening Foundation of The Key Laboratory of Green Pesticide and Agricultural Bioengineering, Ministry of Education, Guizhou University (No. 2018GDGP0101).
Author contribution: All the authors have accepted responsibility for the entire content of this submitted manuscript and approved submission.
Research funding: This research was supported by the Guizhou Provincial Engineering Laboratory for Chemical Drug R&D (No. [2016]5402), Guizhou Provincial Natural Science Foundation (No. [2016]2848, [2017]2835, [2019]1269 and [2020]1Y111), The Project of Postgraduate Scientific Research Fund of Guizhou (No. YJSCXJH[2019]077), National University Students Innovation and Entrepreneurship Training Program (No. 20195200120), The Opening Foundation of The Key Laboratory of Green Pesticide and Agricultural Bioengineering, Ministry of Education, Guizhou University (No. 2018GDGP0101) and National Natural Science Foundation of Guizhou Medical University (NO. 19NSP075).
Conflict of interest statement: The authors declare no conflict of interest relating to the article.
References
1. Brauer, VS, Rezende, CP, Pessoni, AM, Paula, RG, Rangappa, SK, Nayaka, SC, et al. Antifungal agents in agriculture: friends and foes of public health. Biomolecules 2019;9:521. https://doi.org/10.3390/biom9100521.Suche in Google Scholar
2. León, A, Del-Ángel, M, Ávila, JL, Delgado, G. Phthalides: distribution in nature, chemical reactivity, synthesis, and biological activity. Prog Chem Org Nat Prod 2017;104:127–246. https://doi.org/10.1007/978-3-319-45618-8_2.Suche in Google Scholar
3. Beck, JJ, Chou, SC. The structural diversity of phthalides from the apiaceae. J Nat Prod 2007;70:891–900. https://doi.org/10.1021/np0605586.Suche in Google Scholar
4. Sim, Y, Shin, S. Combinatorial anti-trichophyton effects of ligusticum chuanxiong essential oil components with antibiotics. Arch Pharm Res 2008;31:497–502. https://doi.org/10.1007/s12272-001-1184-7.Suche in Google Scholar
5. Teng, CM, Chen, WY, Ko, WC, Ouyang, C. Antiplatelet effect of butylidenephthalide. Biochim Biophys Acta 1987;924:375–82. https://doi.org/10.1016/0304-4165(87)90151-6.Suche in Google Scholar
6. Long, FY, Shi, MQ, Zhou, HJ, Liu, DL, Sang, N, Du, JR. Klotho upregulation contributes to the neuroprotection of ligustilide against cerebral ischemic injury in mice. Eur J Phamacol 2018;820:198–205. https://doi.org/10.1016/j.ejphar.2017.12.019.Suche in Google Scholar
7. Chiu, SC, Chen, SP, Huang, SY, Wang, MJ, Lin, SZ, Harn, HJ, et al. Induction of apoptosis coupled to endoplasmic reticulum stress in human prostate cancer cells by n-butylidenephthalide. PLoS One 2012;7: e33742. https://doi.org/10.1371/journal.pone.0033742.Suche in Google Scholar
8. Fu, RH, Hran, HJ, Chu, CL, Huang, CM, Liu, SP, Wang, YC, et al. Lipopolysaccharide-stimulated activation of murine DC2.4 cells isattenuated by n-butylidenephthalide through suppression of the NF-kappaB pathway. Biotechnol Lett 2011;33:903–10. https://doi.org/10.1007/s10529-011-0528-5.Suche in Google Scholar
9. Meepagala, K, Sturtz, G, Wedgem, CE, Schraderm, KK, Duke, SO. Phytotoxic and antifungal compounds from two apiaceae species, Lomatium clifornicum and Ligusicum hultenii, rich sources of z-ligustilide and apiol, respectively. J Chem Ecol 2005;31:1567–78. https://doi.org/10.1007/s10886-005-5798-8.Suche in Google Scholar
10. Tsukamoto, T, Ishkawa, U, Miyazawa, M. Larvicidal and adulticidal activity of alkylphthalide derivatives from rhizome of Cnidium officinale against Drosophila melanogaster. J Agric Food Chem 2005;53:5553–49. https://doi.org/10.1021/jf050110v.Suche in Google Scholar
11. Xu, H, Fan, LL. Antifungal agents. Part 4: synthesis and antifungal activities of novel indole[1,2-c]-1,2,4-benzotriazine derivatives against phytopathogenic fungi in vitro. Eur J Med Chem 2011;46:364–9. https://doi.org/10.1016/j.ejmech.2010.10.022.Suche in Google Scholar
12. Xu, H, Fan, LL. Synthesis and antifungal activities of novel 5,6-dihydro-indolo[1,2-a]quinoxaline derivatives. Eur J Med Chem 2011;46:1919–25. https://doi.org/10.1016/j.ejmech.2011.02.035.Suche in Google Scholar
13. Fan, LL, Luo, BL, Luo, ZF, Zhang, L, Fan, JD, Xue, W, et al. Synthesis and antifungal activities of 3-substituted phthalide derivatives. Z Naturforsch B 2019;74:811–8. https://doi.org/10.1515/znb-2019-0110.Suche in Google Scholar
14. Fan, LL, Luo, ZF, Li, Y, Liu, XY, Fan, JD, Xue, W, et al. Synthesis and antifungal activity of imidazo[1,2-b]pyridazine derivatives against phytopathogenic fungi. Bioorg Med Chem Lett 2020;30:127139. https://doi.org/10.1016/j.bmcl.2020.127139.Suche in Google Scholar
15. Xu, HY, Jia, A, Hou, EH, Liu, ZY, Yang, R, Yang, RG, et al. Natural product-based fungicides discovery: design, synthesis and antifungal activities of some sarisan analogues containing 1,3,4-oxadiazole moieties. Chem Biodivers 2020;17: e1900570. https://doi.org/10.1002/cbdv.201900570.Suche in Google Scholar
16. Tian, YE, Sun, D, Yang, JM, Che, ZP, Liu, SM, Lin, XM, et al. Synthesis of sulfonate derivatives of maltol and their biological activity against Phytophthora capsici and Bursaphelenchus xylophilus in vitro. J Asian Nat Prod Res 2020;22:578–87. https://doi.org/10.1080/10286020.2019.1608958.Suche in Google Scholar
17. Zhu, T, Li, Y, Fan, LL, Chen, WZ, Tang, L. Synthesis and anti-platelet aggregation activity evaluation of ligustrazine and 3-n-butylphthalide derivatives. Chemical Reagents 2017;39:353–6.Suche in Google Scholar
18. Wang, XL, Wang, LN, Huang, ZJ, Sheng, X, Li, TT, Ji, H, et al. Synthesis and biological evaluation of nitric oxide releasing derivatives of 6-amino-3-n-butylphthalide as potential antiplatelet agents. Bioorgan Med Chem Lett 2013;23:1985–8. https://doi.org/10.1016/j.bmcl.2013.02.035.Suche in Google Scholar
© 2020 Zhongfu Luo et al., published by De Gruyter, Berlin/Boston
This work is licensed under the Creative Commons Attribution 4.0 International License.
Artikel in diesem Heft
- Frontmatter
- Review Article
- A systematic review of botany, phytochemicals and pharmacological properties of “Hoja santa” (Piper auritum Kunth)
- Research Articles
- Inhibition of chikusetsusaponin IVa on inflammatory responses in RAW264.7 cell line via MAPK pathway
- Potential insecticidal activity of aminonaphthoquinone Mannich bases derived from lawsone and their copper (II) complex derivatives
- Design and synthesis of novel n-butyphthalide derivatives as promising botanical fungicides
- Cotinus coggygria Scop. induces cell cycle arrest, apoptosis, genotoxic effects, thermodynamic and epigenetic events in MCF7 breast cancer cells
- Elaeocarpus floribundus Bl. seeds as a new source of bioactive compounds with promising antioxidant and antimicrobial properties
- Structural elucidation and neuroprotective activities of lignans from the flower buds of Magnolia biondii Pamp.
- Distillation time effecting on the composition of Origanum floribundum essential oils and their antioxidant and antimicrobial activities
- Root essential oil of Chrysopogon zizanioides relaxes rat isolated thoracic aorta – an ex vivo approach
- Synergistic antibacterial combination of Lavandula latifolia Medik. essential oil with camphor
Artikel in diesem Heft
- Frontmatter
- Review Article
- A systematic review of botany, phytochemicals and pharmacological properties of “Hoja santa” (Piper auritum Kunth)
- Research Articles
- Inhibition of chikusetsusaponin IVa on inflammatory responses in RAW264.7 cell line via MAPK pathway
- Potential insecticidal activity of aminonaphthoquinone Mannich bases derived from lawsone and their copper (II) complex derivatives
- Design and synthesis of novel n-butyphthalide derivatives as promising botanical fungicides
- Cotinus coggygria Scop. induces cell cycle arrest, apoptosis, genotoxic effects, thermodynamic and epigenetic events in MCF7 breast cancer cells
- Elaeocarpus floribundus Bl. seeds as a new source of bioactive compounds with promising antioxidant and antimicrobial properties
- Structural elucidation and neuroprotective activities of lignans from the flower buds of Magnolia biondii Pamp.
- Distillation time effecting on the composition of Origanum floribundum essential oils and their antioxidant and antimicrobial activities
- Root essential oil of Chrysopogon zizanioides relaxes rat isolated thoracic aorta – an ex vivo approach
- Synergistic antibacterial combination of Lavandula latifolia Medik. essential oil with camphor